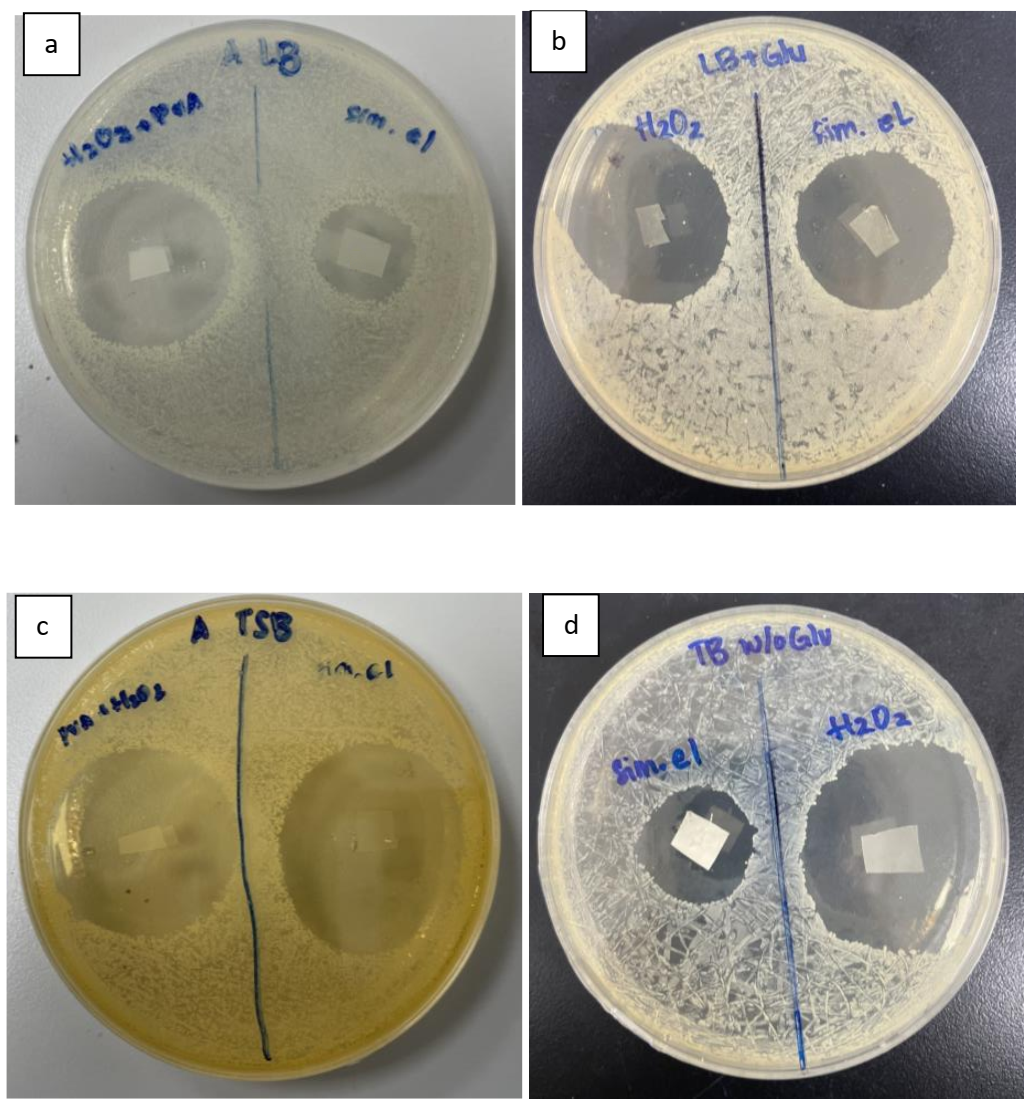
Membranes 11 00997 g007

Nanofibrous Membrane with Encapsulated Glucose Oxidase for Self-Sustained Antimicrobial Applications
Abstract
:1. Introduction
2. Materials and Methods
2.1. Materials
2.2. GOx Encapsulation: Simultaneous Electrospinning of PVA/GOx and PVA/Glucose
2.3. GA Vapor Cross-Linking
2.4. Characterization
2.5. Hydrogen Peroxide Generation Detection and Sustainability Tests
2.6. Antimicrobial Activity of the GOx Encapsulated PVA Nanofibrous Mat
3. Results and Discussion
3.1. GOx Encapsulation
3.2. Sustained Release of Hydrogen Peroxide
3.3. Antimicrobial Activity
4. Conclusions
Supplementary Materials
Author Contributions
Funding
Acknowledgments
Conflicts of Interest
References
- Hanušová, K.; Vápenka, L.; Dobiáš, J.; Mišková, L. Development of Antimicrobial Packaging Materials with Immobilized Glucose Oxidase and Lysozyme. Cent. Eur. J. Chem. 2013, 11, 1066–1078. [Google Scholar] [CrossRef]
- Thallinger, B.; Prasetyo, E.N.; Nyanhongo, G.S.; Guebitz, G.M. Antimicrobial Enzymes: An Emerging Strategy to Fight Microbes and Microbial Biofilms. Biotechnol. J. 2013, 8, 97–109. [Google Scholar] [CrossRef] [PubMed]
- Fuglsang, C.C.; Johansen, C.; Christgau, S.; Adler-Nissen, J. Antimicrobial Enzymes: Applications and Future Potential in the Food Industry. Trends Food Sci. Technol. 1995, 6, 390–396. [Google Scholar] [CrossRef]
- Zia, M.A.; Riaz, A.; Rasul, S.; Abbas, R.Z. Evaluation of Antimicrobial Activity of Glucose Oxidase from Aspergillus Niger EBL-A and Penicillium Notatum. Braz. Arch. Biol. Technol. 2013, 56, 956–961. [Google Scholar] [CrossRef] [Green Version]
- Bankar, S.B.; Bule, M.V.; Singhal, R.S.; Ananthanarayan, L. Glucose Oxidase—An Overview. Biotechnol. Adv. 2009, 27, 489–501. [Google Scholar] [CrossRef]
- Tiina, M. Antibacterial Effect of the Glucose Oxidase-Glucose System on Food-Poisoning Organisms. Int. J. Food Microbiol. 1989, 8, 165–174. [Google Scholar] [CrossRef]
- Ríos-Castillo, A.G.; González-Rivas, F.; Rodríguez-Jerez, J.J. Bactericidal Efficacy of Hydrogen Peroxide-Based Disinfectants Against Gram-Positive and Gram-Negative Bacteria on Stainless Steel Surfaces. J. Food Sci. 2017, 82, 2351–2356. [Google Scholar] [CrossRef]
- Ramachandran, S.; Fontanille, P.; Pandey, A.; Larroche, C. Gluconic Acid: Properties, Applications and Microbial Production. Food Technol. Biotechnol. 2006, 44, 185–195. [Google Scholar]
- Zhao, L.; Wang, L.; Zhang, Y.; Xiao, S.; Bi, F.; Zhao, J.; Gai, G.; Ding, J. Glucose Oxidase-Based Glucose-Sensitive Drug Delivery for Diabetes Treatment. Polymers 2017, 9, 255. [Google Scholar] [CrossRef]
- Anusha, J.R.; Raj, C.J.; Cho, B.-B.; Fleming, A.T.; Yu, K.-H.; Kim, B.C. Amperometric Glucose Biosensor Based on Glucose Oxidase Immobilized over Chitosan Nanoparticles from Gladius of Uroteuthis Duvauceli. Sens. Actuators B Chem. 2015, 215, 536–543. [Google Scholar] [CrossRef]
- Liu, Y.; Nan, X.; Shi, W.; Liu, X.; He, Z.; Sun, Y.; Ge, D. A Glucose Biosensor Based on the Immobilization of Glucose Oxidase and Au Nanocomposites with Polynorepinephrine. RSC Adv. 2019, 9, 16439–16446. [Google Scholar] [CrossRef] [Green Version]
- Liu, X.; Cai, Z.; Gao, N.; Ye, S.; Tao, T.; He, H.; Chang, G.; He, Y. Controllable Preparation of (200) Facets Preferential Oriented Silver Nanowires for Non-Invasive Detection of Glucose in Human Sweat. Smart Mater. Med. 2021, 2, 150–157. [Google Scholar] [CrossRef]
- Martins, R.F.; Plieva, F.M.; Santos, A.; Hatti-Kaul, R. Integrated Immobilized Cell Reactor-Adsorption System for β-Cyclodextrin Production: A Model Study Using PVA-Cryogel Entrapped Bacillus Agaradhaerens Cells. Biotechnol. Lett. 2003, 25, 1537–1543. [Google Scholar] [CrossRef]
- Soto, J.; Hughes, T.; Li, Y.S. Silicon-Based Glucose Oxidase Working Electrode for Glucose Sensing. ACS Omega 2019, 4, 18312–18316. [Google Scholar] [CrossRef] [Green Version]
- Hecht, H.J.; Schomburg, D.; Kalisz, H.; Schmid, R.D. The 3D Structure of Glucose Oxidase from Aspergillus Niger. Implications for the Use of GOD as a Biosensor Enzyme. Biosens. Bioelectron. 1993, 8, 197–203. [Google Scholar] [CrossRef]
- Wang, Z.-G.; Wan, L.-S.; Liu, Z.-M.; Huang, X.-J.; Xu, Z.-K. Enzyme Immobilization on Electrospun Polymer Nanofibers: An Overview. J. Mol. Catal. B Enzym. 2009, 56, 189–195. [Google Scholar] [CrossRef]
- Puttananjegowda, K.; Taksi, A.; Thomas, S. Perspective—Electrospun Nanofibrous Structures for Electrochemical Enzymatic Glucose Biosensing: A Perspective. J. Electrochem. Soc. 2020, 167, 037553. [Google Scholar] [CrossRef]
- Guilbault, G.G.; Lubrano, G.J. An Enzyme Electrode for the Amperometric Determination of Glucose. Anal. Chim. Acta 1973, 64, 439–455. [Google Scholar] [CrossRef]
- Senthamizhan, A.; Balusamy, B.; Uyar, T. Glucose Sensors Based on Electrospun Nanofibers: A Review. Anal. Bioanal. Chem. 2016, 408, 1285–1306. [Google Scholar] [CrossRef]
- Zhao, Y.-T.; Zhang, J.; Gao, Y.; Liu, X.-F.; Liu, J.-J.; Wang, X.-X.; Xiang, H.-F.; Long, Y.-Z. Self-Powered Portable Melt Electrospinning for in Situ Wound Dressing. J. Nanobiotechnol. 2020, 18, 111. [Google Scholar] [CrossRef]
- Massarelli, E.; Silva, D.; Pimenta, A.F.R.; Fernandes, A.I.; Mata, J.L.G.; Armês, H.; Salema-Oom, M.; Saramago, B.; Serro, A.P. Polyvinyl Alcohol/Chitosan Wound Dressings Loaded with Antiseptics. Int. J. Pharm. 2021, 593, 120110. [Google Scholar] [CrossRef]
- Arampatzis, A.S.; Kontogiannopoulos, K.N.; Theodoridis, K.; Aggelidou, E.; Rat, A.; Willems, A.; Tsivintzelis, I.; Papageorgiou, V.P.; Kritis, A.; Assimopoulou, A.N. Electrospun Wound Dressings Containing Bioactive Natural Products: Physico-Chemical Characterization and Biological Assessment. Biomater. Res. 2021, 25, 23. [Google Scholar] [CrossRef]
- Azimi, B.; Maleki, H.; Zavagna, L.; de la Ossa, J.G.; Linari, S.; Lazzeri, A.; Danti, S. Bio-Based Electrospun Fibers for Wound Healing. J. Funct. Biomater. 2020, 11, 67. [Google Scholar] [CrossRef]
- Samadian, H.; Zamiri, S.; Ehterami, A.; Farzamfar, S.; Vaez, A.; Khastar, H.; Alam, M.; Ai, A.; Derakhshankhah, H.; Allahyari, Z.; et al. Electrospun Cellulose Acetate/Gelatin Nanofibrous Wound Dressing Containing Berberine for Diabetic Foot Ulcer Healing: In Vitro and in Vivo Studies. Sci. Rep. 2020, 10, 8312. [Google Scholar] [CrossRef]
- Huang, C.-L.; Lee, K.-M.; Liu, Z.-X.; Lai, R.-Y.; Chen, C.-K.; Chen, W.-C.; Hsu, J.-F. Antimicrobial Activity of Electrospun Polyvinyl Alcohol Nanofibers Filled with Poly[2-(Tert-Butylaminoethyl) Methacrylate]-Grafted Graphene Oxide Nanosheets. Polymers 2020, 12, 1449. [Google Scholar] [CrossRef]
- Wei, Z.; Wang, L.; Zhang, S.; Chen, T.; Yang, J.; Long, S.; Wang, X. Electrospun Antibacterial Nanofibers for Wound Dressings and Tissue Medicinal Fields: A Review. J. Innov. Opt. Health Sci. 2020, 13, 2030012. [Google Scholar] [CrossRef]
- Mendes, L.G.; Ferreira, F.V.; Sielski, M.S.; Livi, S.; Rocco, S.A.; Sforça, M.L.; Burga-Sánchez, J.; Vicente, C.P.; Mei, L.H.I. Electrospun Nanofibrous Architectures of Thrombin-Loaded Poly(Ethylene Oxide) for Faster in Vivo Wound Clotting. ACS Appl. Bio Mater. 2021, 4, 5240–5250. [Google Scholar] [CrossRef]
- Gao, C.; Zhang, L.; Wang, J.; Jin, M.; Tang, Q.; Chen, Z.; Cheng, Y.; Yang, R.; Zhao, G. Electrospun Nanofibers Promote Wound Healing: Theories, Techniques, and Perspectives. J. Mater. Chem. B 2021, 9, 3106–3130. [Google Scholar] [CrossRef] [PubMed]
- Liu, X.; Xu, H.; Zhang, M.; Yu, D.-G. Electrospun Medicated Nanofibers for Wound Healing: Review. Membranes 2021, 11, 770. [Google Scholar] [CrossRef] [PubMed]
- Rivera-Hernández, G.; Antunes-Ricardo, M.; Martínez-Morales, P.; Sánchez, M.L. Polyvinyl Alcohol Based-Drug Delivery Systems for Cancer Treatment. Int. J. Pharm. 2021, 600, 120478. [Google Scholar] [CrossRef]
- Jensen, B.E.B.; Dávila, I.; Zelikin, A.N. Poly(Vinyl Alcohol) Physical Hydrogels: Matrix-Mediated Drug Delivery Using Spontaneously Eroding Substrate. J. Phys. Chem. B 2016, 120, 5916–5926. [Google Scholar] [CrossRef]
- Li, J.K.; Wang, N.; Wu, X.S. Poly(Vinyl Alcohol) Nanoparticles Prepared by Freezing–Thawing Process for Protein/Peptide Drug Delivery. J. Control. Release 1998, 56, 117–126. [Google Scholar] [CrossRef]
- Piacentini, E.; Bazzarelli, F.; Poerio, T.; Albisa, A.; Irusta, S.; Mendoza, G.; Sebastian, V.; Giorno, L. Encapsulation of Water-Soluble Drugs in Poly (Vinyl Alcohol) (PVA)- Microparticles via Membrane Emulsification: Influence of Process and Formulation Parameters on Structural and Functional Properties. Mater. Today Commun. 2020, 24, 100967. [Google Scholar] [CrossRef]
- Karim, A.A.; Tan, E.; Loh, X.J. Encapsulation of Vitamin C with Its Protection from Oxidation by Poly(Vinyl Alcohol). J. Mol. Eng. Mater. 2017, 5, 1750013. [Google Scholar] [CrossRef]
- Jia, Y.-T.; Gong, J.; Gu, X.-H.; Kim, H.-Y.; Dong, J.; Shen, X.-Y. Fabrication and Characterization of Poly (Vinyl Alcohol)/Chitosan Blend Nanofibers Produced by Electrospinning Method. Carbohydr. Polym. 2007, 67, 403–409. [Google Scholar] [CrossRef]
- Wu, L.; Yuan, X.; Sheng, J. Immobilization of Cellulase in Nanofibrous PVA Membranes by Electrospinning. J. Membr. Sci. 2005, 250, 167–173. [Google Scholar] [CrossRef]
- Hulupi, M.; Haryadi, H. Synthesis and Characterization of Electrospinning PVA Nanofiber-Crosslinked by Glutaraldehyde. Mater. Today: Proc. 2019, 13, 199–204. [Google Scholar] [CrossRef]
- Destaye, A.G.; Lin, C.-K.; Lee, C.-K. Glutaraldehyde Vapor Cross-Linked Nanofibrous PVA Mat with in Situ Formed Silver Nanoparticles. ACS Appl. Mater. Interfaces 2013, 5, 4745–4752. [Google Scholar] [CrossRef]
- Ren, G.; Xu, X.; Liu, Q.; Cheng, J.; Yuan, X.; Wu, L.; Wan, Y. Electrospun Poly(Vinyl Alcohol)/Glucose Oxidase Biocomposite Membranes for Biosensor Applications. React. Funct. Polym. 2006, 66, 1559–1564. [Google Scholar] [CrossRef]
- Wang, Y.; Hsieh, Y.L. Immobilization of Lipase Enzyme in Polyvinyl Alcohol (PVA) Nanofibrous Membranes. J. Membr. Sci. 2008, 309, 73–81. [Google Scholar] [CrossRef]
- Long, J.; Nand, A.V.; Bunt, C.; Seyfoddin, A. Controlled Release of Dexamethasone from Poly(Vinyl Alcohol) Hydrogel. Pharm. Dev. Technol. 2019, 24, 839–848. [Google Scholar] [CrossRef]
- Begander, B.; Huber, A.; Döring, M.; Sperl, J.; Sieber, V. Development of an Improved Peroxidase-Based High-Throughput Screening for the Optimization of D-Glycerate Dehydratase Activity. Int. J. Mol. Sci. 2020, 21, 335. [Google Scholar] [CrossRef] [PubMed] [Green Version]
- Chen, Y.; Zhong, Q.; Wang, Y.; Yuan, C.; Qin, X.; Xu, Y. Colorimetric Detection of Hydrogen Peroxide and Glucose by Exploiting the Peroxidase-like Activity of Papain. RSC Adv. 2019, 9, 16566–16570. [Google Scholar] [CrossRef] [Green Version]
- Nicol, M.J.; Duke, F.R. Substrate Inhibition with Glucose Oxidase. J. Biol. Chem. 1966, 241, 4292–4293. [Google Scholar] [CrossRef]
- Lee, I.; Cheon, H.J.; Adhikari, M.D.; Tran, T.D.; Yeon, K.-M.; Kim, M.I.; Kim, J. Glucose Oxidase-Copper Hybrid Nanoflowers Embedded with Magnetic Nanoparticles as an Effective Antibacterial Agent. Int. J. Biol. Macromol. 2020, 155, 1520–1531. [Google Scholar] [CrossRef] [PubMed]

Publisher’s Note: MDPI stays neutral with regard to jurisdictional claims in published maps and institutional affiliations. |
© 2021 by the authors. Licensee MDPI, Basel, Switzerland. This article is an open access article distributed under the terms and conditions of the Creative Commons Attribution (CC BY) license (https://creativecommons.org/licenses/by/4.0/).
Share and Cite
Leonarta, F.; Lee, C.-K. Nanofibrous Membrane with Encapsulated Glucose Oxidase for Self-Sustained Antimicrobial Applications. Membranes 2021, 11, 997. https://doi.org/10.3390/membranes11120997
Leonarta F, Lee C-K. Nanofibrous Membrane with Encapsulated Glucose Oxidase for Self-Sustained Antimicrobial Applications. Membranes. 2021; 11(12):997. https://doi.org/10.3390/membranes11120997
Chicago/Turabian StyleLeonarta, Fernaldy, and Cheng-Kang Lee. 2021. "Nanofibrous Membrane with Encapsulated Glucose Oxidase for Self-Sustained Antimicrobial Applications" Membranes 11, no. 12: 997. https://doi.org/10.3390/membranes11120997
APA StyleLeonarta, F., & Lee, C.-K. (2021). Nanofibrous Membrane with Encapsulated Glucose Oxidase for Self-Sustained Antimicrobial Applications. Membranes, 11(12), 997. https://doi.org/10.3390/membranes11120997
